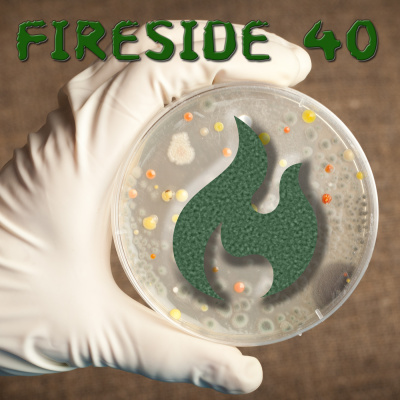
Fireside

Fireside
40 - Rise to a Brave Contagion
- Autor: Vários
- Narrador: Vários
- Editora: Podcast
- Duração: 0:42:36
- Mais informações
Informações:
Sinopse
There comes a special time in every week - a time where two friends get together over beer to discuss the various tabletop and video games they have been playing that week. Bringing a wealth of experience and applying detailed reviewer's acumen they are able to intelligently provide their listeners with all the info they need to make important life decisions with regards to gaming. Then there's Fireside - a similar premise but without any of the class or deductive intelligence the previous two lines may have conveyed! This week we discuss Pandemic: Contagion and Rise to Power before starting on Final Fantasy: Brave Exius and having to cut it short due to technical difficulties. Fortunately we have the delicious Gage Roads Breakwater Australian Pale Ale to help us through!0:00 - Intro1:04 - Quest for Sponsorship - Gage Roads Breakwater Pale Ale2:33 - Pandemic: Contagion13:01 - Rise to Power25:58 - Final Fantasy: Brave Exvius34:25 - Message from the Editor35:28 - Gage Roads Breakwater ratingVisit this thread t